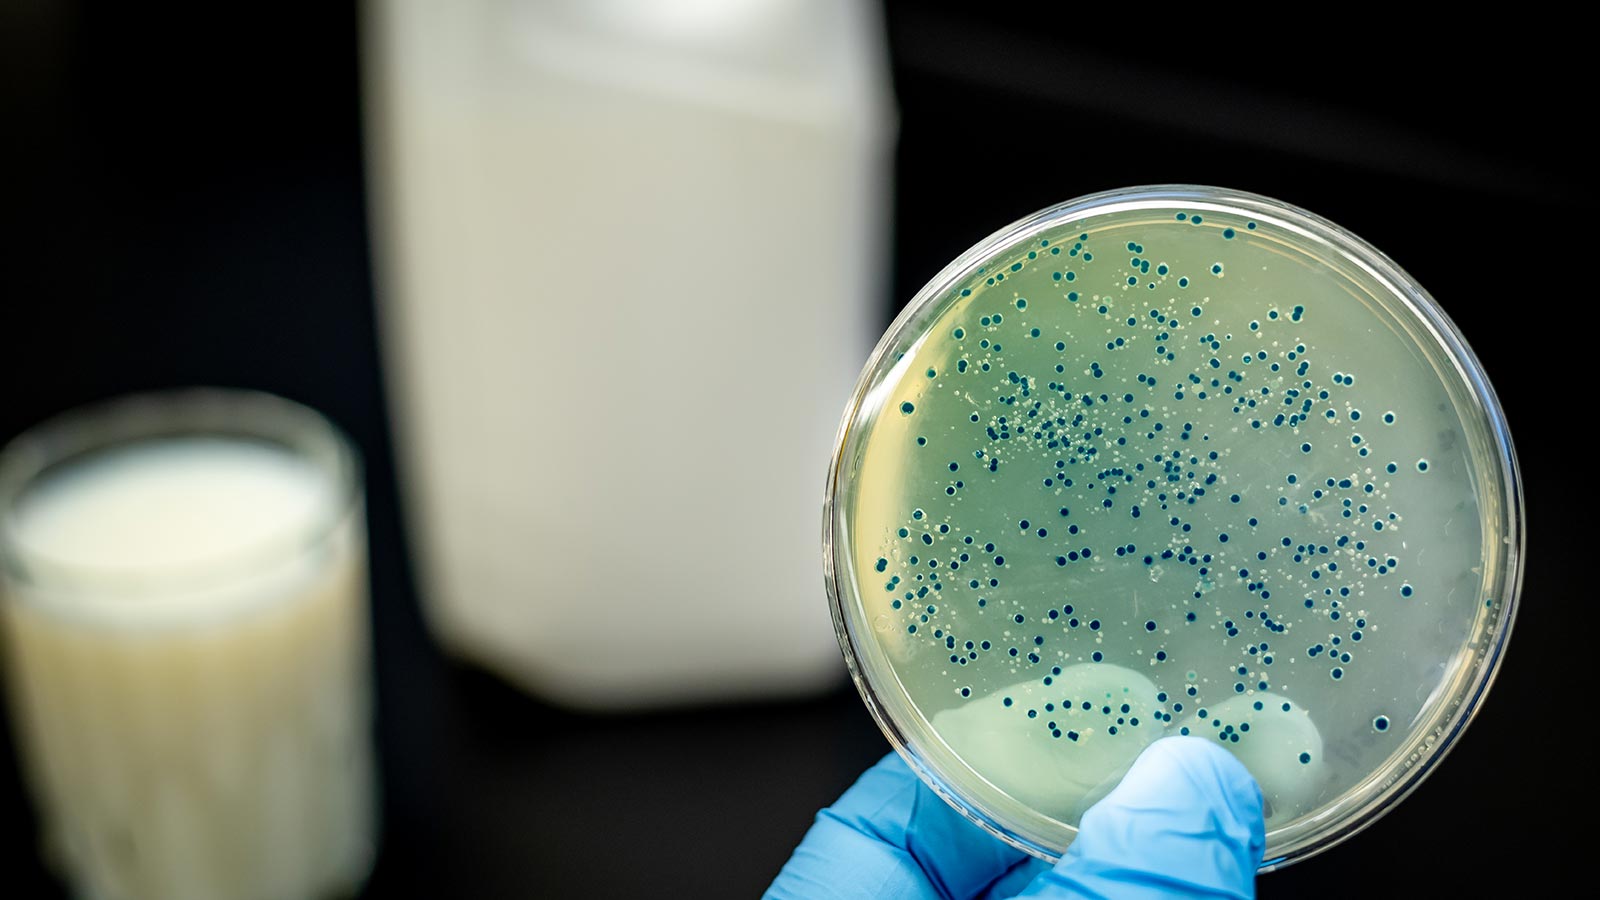
Leche contaminada Francia

Leche infantil contaminada por salmonela: Lactalis retira 37 productos
La salmonela en los lotes de alimentos infantiles del grupo Lactalis sigue siendo noticia. En diciembre se retiraron del mercado lotes de leche en polvo para lactantes y cereales de las marcas Damira, Sanutri y Puleva Bebe. Ahora, Lactalis ha decidido retirar todos los lotes de 37 productos de alimentación infantil, los elaborados en la fábrica francesa contaminada. Si tienes uno de ellos, no lo consumas.
Salmonela en productos infantiles fabricados en Francia
El pasado 22 de diciembre cuando, tras varios casos de salmonelosis las autoridades francesas retiraron masivamente más lotes de leche infantil del grupo Lactalis, Lactalis Nutrición Iberia también retiró del mercado español varios lotes de sus fórmulas infantiles para lactantes. Esos lotes que incluían leche en polvo para lactantes de las marcas Sanutri y Damira, papillas de cereales de Puleva Bebé y un módulo de nutrición a base de maltodextrina en polvo.
En resumen, en ese primer momento se retiraron todos los productos fabricados en la planta francesa de Craon (donde surgió la bacteria de la salmonela) desde el pasado 15 de febrero, como medida de precaución, al estar fabricados en la misma línea de producción que los lotes de las marcas francesas afectadas.
Consulta la lista completa de los productos retirados por AECOSAN
Desde entonces, el problema no se ha resuelto, y de hecho ha ampliado sus proporciones. Hace unos dias se supo de un lactante español afectado por salmonela tras consumir uno de estos productos, y siguen produciéndose casos en toda Europa. Lactalis comunicó que realizaba una parada técnica de la fábrica para emprender medidas de limpieza y desinfección adicionales y en profundidad, pero no ha debido ser suficiente.
Lactalis Ibérica retira 37 productos
En vista de los hechos, por precaución, Lactalis Ibérica ha comunicado el 18 de enero que retira del mercado, de forma voluntaria, todos los lotes de los productos elaborados en la fábrica de Craon. En total los afectados por la retirada son 37 productos:
- Leche en polvo DAMIRA 2000 400G
- Leche en polvo DAMIRA ARROZ HIDROLIZADO 400G
- Leche en polvo DAMIRA ATOPY 400G
- Leche en polvo DAMIRA PRO 1 400 G
- Leche en polvo DAMIRA PRO 1 460G
- Leche en polvo DAMIRA PRO 2 400 G
- Leche en polvo DAMIRA PRO 2 460 G
- Leche en polvo DAMIRA PRO 3 400G
- Leche en polvo LACTODAMIRA 2000 400G
- Leche en polvo SANUTRI AR 800G
- Leche en polvo SANUTRI DIARICAL 400G
- Leche en polvo SANUTRI DIGEST 125G
- Leche en polvo SANUTRI DIGEST 800G
- Leche en polvo SANUTRI NATUR 1 800G
- Leche en polvo SANUTRI NATUR 2 800G
- Leche en polvo SANUTRI NATUR 2 1,4KG
- Leche en polvo SANUTRI NATUR 2 125 G
- Leche en polvo SANUTRI NATUR 3 800G
- Leche en polvo SANUTRI PRETERM 400G
- Leche en polvo SANUTRI SRO 200G
- Leche en polvo PULEVA BEBÉ 1 800G
- Leche en polvo PULEVA BEBÉ 2 800 G
- Leche en polvo PULEVA BEBÉ 2 125 G
- Leche en polvo PULEVA BEBÉ 3 800G
- Leche en polvo PULEVA BEBÉ AR 800G
- Leche en polvo PULEVA BEBÉ DIGEST 800G
- Cereales PULEVA BEBÉ 8 CEREALES CON CACAO FOS 500G
- Cereales PULEVA BEBÉ 8 CEREALES FOS 200 G
- Cereales PULEVA BEBÉ 8 CEREALES FOS 500 G
- Cereales PULEVA BEBÉ CEREALES SIN GLUTEN FOS STICK 17G
- Cereales PULEVA BEBÉ CEREALES SIN GLUTEN FOS 500G
- Cereales PULEVA BEBÉ 8 CEREALES FRUTAS FOS 500G
- Cereales PULEVA BEBÉ 8 CEREALES+GALLETA MARIA FOS 500G
- Cereales PULEVA BEBÉ 8 CEREALES+MIEL 500G
- Leche en polvo para metabolopatías TARANIS NOPHENYL NIÑOS 34 G X 15
- Leche en polvo para metabolopatías TARANIS NOPHENYL LACTANTES 400 G
- Módulo de nutrición MALTODEXTRIDINE BOTE 350 G

La empresa insiste que el consumo del resto de productos y lotes de las marcas Sanutri, Damira y Puleva Bebé son totalmente seguros, incluyendo todos los productos de leche líquida de la marca Puleva Peques, y las papillas de cereales Sanutri y Damira ya que se fabrican en instalaciones ubicadas en España.
Qué hacer si tienes algún producto afectado
Si tuvieras uno de estos lotes afectados abstente de consumirlo, llévalo donde lo compraste y pide la devolución.
Si necesitas más información hay un teléfono que Lactalis Iberia pone a disposición de los consumidores, el 900 102 336 (horario de atención de lunes a viernes 8:30 h a 20:00 h).